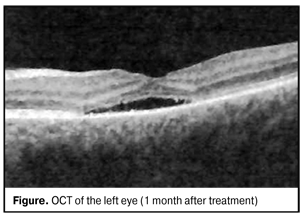

J.ophthalmol.(Ukraine).2016;2:47-49.
|
https://doi.org/10.31288/oftalmolzh201624749 A case of successful laser coagulation in pediatric ophthalmology: a patient with the optic disc pit complicated by serous neuroepithelial detachment I.I. Shevchenko Consultative and diagnostic centre of Dneprovskii district Kyiv (Ukraine) E-mail: irakorsyn@gmail.com Introduction. Optic disk pit has been considered as coloboma located, as a rule, near temporal part of the optic disc. Central serous retinal detachment develops in 50 % of patients. The purpose of the present study was to show practically the possibility to use laser coagulation as an entire method for treatment of optic disc pit complicated by serous neuroepithelial detachment in children. Material and Methods. A patient, 4 y/o, with Jensen’s retinochoroiditis juxtapapillaris, optic disc pit and serous neuroepithelial detachment was followed up. The patient was performed 532 nm laser, optical coherent tomography, visiometry, biomicroscopy, ophthalmoscopy and immunology research. Results. Visual acuity increased from 0.08 to 0.5 after treatment. Neuroepithelial attachment was achieved with residual detachment up to 40 µm. Conclusions. This case demonstrates that laser coagulation of the retina can be used as a separate and minimally invasive method of treatment for patients with optic disk pits complicated by serous neuroepithelial detachment in pediatric ophthalmology.
Key words: optic disc pit, serous neuroepithelial detachment, laser coagulation Introduction Optic disk pit has been considered as coloboma located, as a rule, near temporal part of the optic disc [1, 5]. In 50 % of patients develops central serous retinal detachment. However, pathogenesis of the disease is understudied. Some authors have considered optic disc pit as a variant of optic disc hypoplasia with nerve fibre in-growth retardation. Other authors have associated the formation of pits with the insertion of rudimentary retina folders into intervaginal spaces of the optic nerve [2, 5]. Visual acuity is not decreased if there is no complication. The optic disc is slightly larger than the normal one with an oval or round pit, which size is varied within wide ranges. As a rule, the pit is located in the temporal part of the disc, but sometimes it can pe located in the centre. More often than not, visual field defects have been noted and they can resemble alterations in glaucoma. Pathological changes in the macular area are manifested in serous neuroepithelial detachment and usually developed in juvenility. Fluid has been considered to get under the retina from the vitreous body. The possibility of fluid penetration from subarachnoid space of the optic nerve and leakage from abnormal vessels into the base of the tip has also been discussed [3]. First, serous detachment of the inner retinal layers appears. Afterwards, it develops in the outer retinal layers, which is sometimes accompanied by subretinal complications. Herewith, ophthalmoscopic picture observed can resemble central serous chorioretinopathy [3, 9]. Most of all, pits are detected in ophthalmoscopy in a form of dark spots with sharp margins, sized from ? to 1/8 of disc’s diameter, located in the temporal part near the edge and covered with veiling-like grayish tissue [2, 6]. Treatment The initial stage is observation every three months with relation to spontaneous resolution of neuroepithelial detachment occurred in 25 % of cases. If dynamics is absent, afterwards, laser coagulation of the retina can be performed if vision acuity reduces progressively; at that, coagulators are applied along the temporal margin of the disc. The efficacy of such treatment is 23-35 % [3]. If laser coagulation is not effective, gas tamponade vitrectomy and endolaser coagulation are performed. The operation is effective in 50-70 % of cases [3, 5]. The purpose of the present study is to show practically the possibility to use laser coagulation as an entire method for treatment of optic disc pit complicated by serous neuroepithelial detachment in children. In november 2013, a 4 year old patient P. was taken by her parents to the district ophthalmologists with complaints of yellow-green discharge, both eye redness for 3 days. On ocular examination, the patient had vis OD=0.7; OS=0.5. The patient was diagnosed acute conjunctivitis of both eyes and prescribed antibiotics instillation with her 4-day follow-up visit. On ocular reexamination, the visual acuities were OD = 0.7; OS = 0.2. Cycloplegia examination revealed the absence of OS macular reflex (grayish color in the macular area). Congenital abnormality of eye fundus in both eyes was diagnosed. The patient was referred to consultation in Kiev children clinic hospital. There, on ocular examination, the patient was diagnosed optic disc pit (ODP) in both eyes. On the eye fundus: OD, the optic disc was pale-pink with sharp margins and cyst formation at 11 o’clock; OS, whitish sites of damage were noted in the macular area. Optical coherent tomography was performed and the treatment prescribed was 1.0 ml of betamethasone parabulbarly OS No3, 1 injection per day. After corticosteroids treatment, insignificant decrease in height of neuroepithelial detachment was noted; however, uncorrected visual acuity was OS=0.008-0.1. The patient was referred to SI “Filatov institute of Eye Diseases and Tissue Therapy of the NAMS of Ukraine” in Odessa. Condition on admission was vis OD=1.0; OS=0.2=sph-1.0dcyl-0.5dax30°=0.3. In both eyes, the conjunctiva was pale-pink, smooth, and transparent; the cornea was transparent, brilliant and mirror-like. The content of the anterior chamber was transparent; the pupil was round and 2-4 mm in diameter, mobile; the lens was transparent. The optic disc in both eyes was pale-pink with sharp margins and had optic disc pits and peripappilary chorioretinal scarring with pigmentation. Vessels were of a normal caliber. The patient had parquet fundus of the eye. Macular reflex was clear in the right eye and pathological in the left eye; neuroepithelial detachment was revealed at the macula area. Figure 1 of left eye fundus demonstrates optic disk pit with sharp margins at the temporal part between 5 and 6 o’clock. OCT revealed neuroepithelial detachment with a height of 625 mkm (Fig.1).
The patient was diagnosed Jensen’s retinochoroiditis juxtapapillaris in remission with chorioretinal scarring, optic disc pits in both eyes, and serous neuroepithelial detachment in the left eye. The patient was referred to single-discipline specialists to rule out tuberculosis. The results of the investigation are given below. Immunology QuantiFERON – TBTest (for diagnosing latent Mycobacterium tuberculosis infection) – 0.20 IU/ml - negative Ig G Mycobacteriumtuberculosis (enzyme immunoassay (EIA), blood serum) – 2.6 l Eg/ml – negative EIA (autoimmune disease) - antibodies to double-stranded DNA / Ab – 18.59 l Eg/ml – negative Circulating immune complex (CIC) (blood serum) С1q / СIC C1q – 1.75 µm/ml - negative (CIC) (blood serum) C3d / CICC3d- 0.80 µm/ml - negative Ig Е (blood serum) 23.20 IU/ml - negative Bio/immunochemistry Toxoplasma gondii, HSV 1,2, PCRHCV – negative Instrumental tests Multispiral computed tomography of lungs and mediastinum revealed no signs of focal infiltration. Ultrasound investigation (US) of abdominal cavity organs revealed gallbladder volvulus at gallbladder neck. US for thyroid gland revealed no pathological changes. Treatment On August 12, 2015, restrictive laser coagulation was performed in the left eye (laser, 532 nm; 39 laser exposures; power, 110 mW; exposure dose, 150 mc; diameter, 200 µm). Anti-inflammatory and antioxidant treatment was performed postoperatively. Visual acuity on discharge was OD=1.0; OS=0.2=sph -1.0 D = 0.3. On reexamination on December, 12, 2015, uncorrected visual acuity was OD=1.0; OS=0.3. The right eye was stable and the left eye had no inflammation signs, serous neutoepithelial detachment reduced. To rule out unilateral retinitis pigmentosa, dark adaptation test (ОD = 2.85 with a filter; OS = 1.4 without a filter) was performed and followed by grating-like laser coagulation of the retina in the left eye (laser, 532 nm; 87 laser exposures; power, 80 mW; exposure dose, 140 mc; duration скважность – 200 мс; diameter, 200 µm). Anti-inflammatory and antioxidant treatment was performed postoperatively. On her 1 month follow-up visit, the patient had vis OD=1.0; OS=0.5. OCT revealed residual serous neuroepithelial detachment at macular area (Fig. 2). On reexaminations within 2 months, visual acuity was 0.5 in the left eye.
Discussion Hsu C. L et al has reported on the successful laser surgery in an aged patient with congenital optic disc pits in both eyes [5, 7, 11]. Similar outcomes have been achieved by Cywi?ski A. Et al in 9 patients performing combined treatment as central posterior vitrectomy with removal of posterior hyaloid membrane, laser coagulation and gas tamponade of the vitreous cavity. [4, 8, 10]. Conclusion Restrictive or grating-like laser coagulation of the retina in pediatric ophthalmology can be used as a separate and minimally invasive method of treatment for patients with optic disk pits complicated by serous neuroepithelial detachment.
References 1.Taylor D, Hoyt C. [Pediatric Ophthalmology]. 2007. 248 p. Russian. 2.Avetisov ES, Kovalevskii EI, Khvatova AV. Guidelines for Pediatric Ophthalmology. M.: Meditsina; 1987. 496 p. Russian. 3.Kanski JJ., Milevski SA, Damato BE, Tanner V. [Ocular fundus diseases]. 2009. 424 p. Russian. 4.Cywi?ski A, Ka?u?ny J, Ferda D, Piwo?ska-Lobermajer A. Posterior vitrectomy with gas enotamponade and retinal laser therapy in treatment of patients with macular complications of the optic disk pit. Klin Oczna. 2015; 117(2):83-7. Polish. 5.Hsu CL, Layton CJ. Familial Disoders of the Optic Disk Pit: Presentation of a Mother and Douther Review of the Literature. Case Rep Ophthalmol. 2015 May-Aug; 6(2): 251–9. Doi: 10.1159/000437381. 6.Georgalas I, Ladas I, Georgopoulos G, Petrou P. Optic disk pit: a review. Graefes Arch Clin Exp Ophthalmol. 2011 Aug;249(8):1113-22. doi: 10.1007/s00417-011-1698-5. 7.Imamura Y, Zweifel S, Fujiwara T, Freund K, Spaide R. High-resolution optical coherence tomography findings in optic pit maculopathy. Retina. 2010;30:1104–111. doi: 10.1097/IAE.0b013e3181d87ecb 8.Choudhry N. Double optic pit maculopathy. Ophthalmic Surg Lasers Imaging Retina. 2015 Feb; 46(2):284-6. doi: 10.3928/23258160-20150213-05. 9.Taniguchi EV, Young LH, Shen LQ. Optic nerve pit and associated macular detachment. JAMA Ophthalmol. 2015 Jan; 133(1): e141775. doi: 10.1001/jamaophthalmol. 2014.1775. 10.Lei L, Li T, Ding X, Ma W, Zhu X, Atik A, Hu Y, Tang S. Gas tamponade combined with laser photogoagulation therapy for congenital optic disk pit maculopathy. Eye (Lond). 2015 Jan; 29(1): 106–114. 10.1038/eye.2014.245 11.Gregory-Roberts EM, Mateo C, Corc?stegui B, Schiff WM, Chang LK, Quiroz-Mercado H, Park S, Chang S. Optic disk pit morphology and retinal detachment: optical coherence tomography with intraoperative correlation. Retina. 2013 Feb; 33(2):363-70. doi: 10.1097/IAE.0b013e318263d0a6.
|